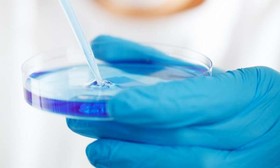
توسعه ابزار تشخیصی مبتنی بر ژنتیک برای سندرم "میلودیسپلاستیک"

سندرم میلودیسپلاستیک
برای دسترسی به اخبار قدیمیتر، در منوی مربوطه سال و ماه را محدود کنید.
-
توسعه ابزار تشخیصی مبتنی بر ژنتیک برای سندرم "میلودیسپلاستیک"
"میو کلینیک"(Mayo Clinic) که یکی از معتبرترین مراکز و دانشگاههای علوم پزشکی جهان مستقر در آمریکا است، اخیرا یک ابزار تشخیصی مبتنی بر ژنتیک برای "سندرم میلودیسپلاستیک"(myelodysplastic syndrome) توسعه داده است.
